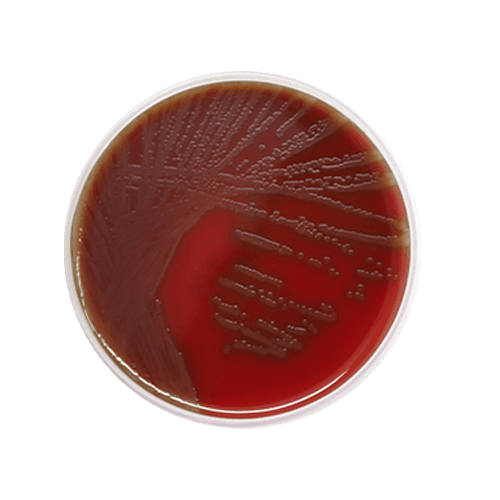

O ágar sangue é um meio de cultura enriquecido que contém sangue de carneiro, permitindo o crescimento de uma ampla variedade de microrganismos. É utilizado principalmente para isolar e identificar bactérias patogênicas e observar suas propriedades hemolíticas, como a hemólise beta (lise completa dos glóbulos vermelhos), hemólise alfa (parcial) e ausência de hemólise. Este meio é essencial para o diagnóstico clínico, especialmente em amostras de fluidos corporais e secreções, ajudando na identificação de infecções bacterianas e na avaliação da virulência de patógenos.